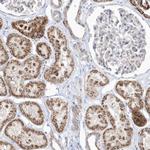
OPA1 Antibody in Immunohistochemistry (IHC)

Search
Invitrogen
OPA1 Polyclonal Antibody
{{$productOrderCtrl.translations['antibody.pdp.commerceCard.promotion.promotions']}}
{{$productOrderCtrl.translations['antibody.pdp.commerceCard.promotion.viewpromo']}}
{{$productOrderCtrl.translations['antibody.pdp.commerceCard.promotion.promocode']}}: {{promo.promoCode}} {{promo.promoTitle}} {{promo.promoDescription}}. {{$productOrderCtrl.translations['antibody.pdp.commerceCard.promotion.learnmore']}}
图: 1 / 9
OPA1 Antibody (PA5-57874) in ICC/IF

Please note: We are reviewing Western blot images included in the antibody testing data in our catalog, including those provided by third parties. Unless expressly labeled or annotated as “raw-unedited”, Western blot images included in the antibody testing data in our catalog may have been edited, optimized or otherwise adjusted for presentation.
产品信息
PA5-57874
种属反应
宿主/亚型
分类
类型
抗原
偶联物
形式
浓度
规格
纯化类型
保存液
内含物
保存条件
运输条件
RRID
产品详细信息
Immunogen sequence: ESIKRHKWND FAEDSLRVIQ HNALEDRSIS DKQQWDAAIY FMEEALQARL KDTENAIENM VGPDWKKRWL YWKNRTQEQC VHNETKNELE KMLKCNE
Highest antigen sequence identity to the following orthologs: Mouse - 95%, Rat - 95%.
靶标信息
OPA1 is a dynamin-related GTPase that is critical for the maintenance of mitochondrial morphology and mtDNA. The most commonly associated phenotype with OPA1 mutations is heterozygous optic atrophy, a heterozygous dominant trait that causes reduced visual clarity and sometimes blindness. The disease usually begins in childhood and increases in severity throughout the life of affected individuals. Usually, this phenotype is attributed to the degeneration of optic nerve fibers. Interestingly, the same type of nerve degeneration seems to be partially causative of certain schizophrenia characteristics. OPA1 dysfunction also seems to be implicated in this case; mitochondrial networks associated with critical nerves seem to link schizophrenia and OPA1. The dysfunction is associated with issues with apoptosis and normal cellular metabolic regulation, all regulated through OPA1.
仅用于科研。不用于诊断过程。未经明确授权不得转售。
篇参考文献 (0)
生物信息学
蛋白别名: Dynamin-like GTPase OPA1, mitochondrial; Optic atrophy protein 1
基因别名: KIAA0567; OPA1
Entrez Gene ID: (Human) 4976




